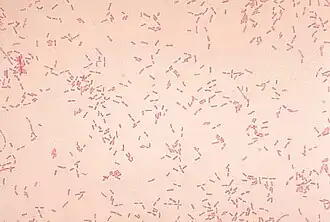
Alcaligenes faecalis, окраска по методу Грама

Alcaligenes faecalis
| Alcaligenes faecalis | ||||||||||
|---|---|---|---|---|---|---|---|---|---|---|
![]() Alcaligenes faecalis, окраска по методу Грама | ||||||||||
| Научная классификация | ||||||||||
|
Домен: Тип: Класс: Бета-протеобактерии Порядок: Burkholderiales Семейство: Род: Alcaligenes Вид: Alcaligenes faecalis |
||||||||||
| Международное научное название | ||||||||||
| Alcaligenes faecalis Castellani and Chalmers 1919 emend. Rehfuss and Urban 2005 | ||||||||||
| ||||||||||
Alcaligenes faecalis (лат.) — вид грамотрицательных палочковидных бактерий из семейства Alcaligenaceae, типовой вид рода Alcaligenes. Первоначально изолирована из фекалий, затем была обнаружена в почве и воде.
Известно 3 подвида Alcaligenes faecalis[1]:
- Alcaligenes faecalis subsp. faecalis (Castellani and Chalmers 1919) Austin et al. 1981
- Alcaligenes faecalis subsp. parafaecalis Schroll et al. 2001
- Alcaligenes faecalis subsp. phenolicus Rehfuss and Urban 2006
Ранее выделявшийся подвид Alcaligenes faecalis subsp. homari Austin et al. 1981 синонимизирован с видом Halomonas aquamarina (ZoBell and Upham 1944) Dobson and Franzmann 1996[1].
Биологические свойства
Морфология

Грамотрицательные палочки или коккобациллы размером 0,5—1,2 × 1—3 мкм, не образуют спор, подвижные за счёт наличия от одного до девяти жгутиков, расположенных перетрихиально.
Культуральные свойства
Хемоорганогетеротроф, облигатный аэроб, Alcaligenes faecalis subsp. faecalis способна к нитритному дыханию, образуют оксидазу и каталазу. Оптимальная температура роста 20—37 °С. Образует непигментированные либо серовато-белые, прозрачные до мутных, плоские или слегка выпуклые круглые, гладкие (изредка шероховатые) колонии с неправильным краем на питательном агар-агаре. Не способны использовать углеводы как единственный источник углерода, способны утилизировать ацетат, пропионат, бутират, цитрат, аланин и некоторые другие аминокислоты[2]. Некоторые штаммы способны окислять арсенит[3]. Alcaligenes faecalis subsp. phenolicus способна к биодеградации фенола[4]. Alcaligenes faecalis способна продуцировать оксид азота(I)[5].
Патогенность
Alcaligenes faecalis является условно-патогенным микроорганизмом, способна вызывать септицемию и менингит у новорождённых[6], интраабдоминальные инфекции у взрослых[7]. Также вызывает заболевания у домашней птицы — в частности респираторные заболевания у цыплят[8], инфекции у индюков[9], показано цитотоксическое действие Alcaligenes faecalis на культуру клеток трахеи индеек[10].
Применение
Alcaligenes faecalis используется человеком как продуцент нестандартных аминокислот[11], также интерес представляет фермент пенициллинацилаза Alcaligenes faecalis, использующаяся для производства полусинтетических антибиотиков[12][13], также Alcaligenes faecalis является продуцентом 6-гидроксипиколиновой кислоты[14], а также биополимера глюкозы курдлана (пищевая добавка E424, en:Curdlan), образующего термически необратимые гели, используется в том числе для производства мембран для ультрафильтрации[15][16].
Примечания
- 1 2 Genus Alcaligenes : [англ.] // LPSN. (Дата обращения: 6 января 2020).
- ↑ Bergey’s Manual of Systematic Bacteriology. Дата обращения: 1 октября 2017. Архивировано 31 января 2010 года.
- ↑ Metabolic energy from arsenite oxidation in Alcaligenes faecalis | J. Phys. IV France Архивная копия от 24 мая 2008 на Wayback Machine Архивировано 24 мая 2008 года.
- ↑ Alcaligenes faecalis subsp. phenolicus subsp. nov. a phenol-degrading, denitrifying bacterium isolated from a graywater bioprocessor. Дата обращения: 9 сентября 2008. Архивировано из оригинала 8 августа 2014 года.
- ↑ Nitrous oxide production by Alcaligenes faecalis under transient and dynamic aerobic and anaerobic conditions — Otte et al. 62 (7): 2421 — Applied and Environmental Microbiology. Дата обращения: 9 сентября 2008. Архивировано 7 сентября 2008 года.
- ↑ SpringerLink — Journal Article (недоступная ссылка)
- ↑ Results of a Randomized Trial Comparing Sequential Intraveno… : Annals of Surgery
- ↑ https://www.jstor.org/pss/1589991
- ↑ The effect of combined and separate infection by alcaligenes faecalis and paramyxovirus (yucaipa) on the surface morphology of the trachea in Turkey poults — Avian Pathology
- ↑ https://www.jstor.org/pss/1590214
- ↑ Prevention of incorporation of non-standard amino acids into protein — Patent Application 20070009995. Дата обращения: 9 сентября 2008. Архивировано 4 марта 2016 года.
- ↑ Purification and Characterization of Alcaligenes faecalis Penicillin G Acylase Expressed in Bacillus subtilis Архивная копия от 2 октября 2006 на Wayback Machine Архивированная копия. Дата обращения: 7 мая 2018. Архивировано 2 октября 2006 года.
- ↑ Ясная Анна Сергеевна. Клонирование и экспрессия в E. coli пенициллинацилаз для получения мутантных форм с улучшенными свойствами (2009). Дата обращения: 12 сентября 2010. (недоступная ссылка)
- ↑ U.S. Patent 5 268 294
- ↑ C7821 Curdlan from Alcaligenes faecalis
- ↑ Биотехнология: Монография. Единое окно доступа к образовательным ресурсам